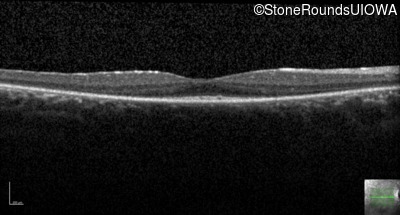
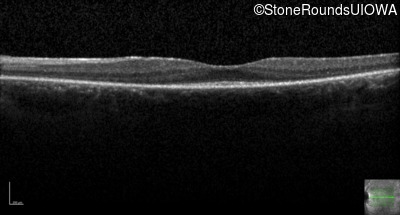

Case
SR49
Student Mode
AR Retinitis Pigmentosa (IA1aiii)
Female
Female
Hidden
SR49
Student Mode
AR Retinitis Pigmentosa (IA1aiii)
Female
Female
History
This 24 year old woman first noticed difficulty tracking a volleyball when she was 15 years old. More recently she has been reluctant to go running because of her constricted visual field inferiorly. She did not have any nyctalopia when she was first symptomatic but has developed it more recently.
Diagnosis & molecular findings
| Disease | Gene | Allele 1 variant(s) | Allele 2 variant(s) | Inheritance mode |
|---|---|---|---|---|
| AR Retinitis Pigmentosa | USH2A | Cys759Phe TGC>TTC | Glu4304 del1gA | AR |
Disease:
Gene:
Allele 1:
Cys759Phe TGC>TTC
Allele 2:
Glu4304 del1gA
Inheritance:
AR